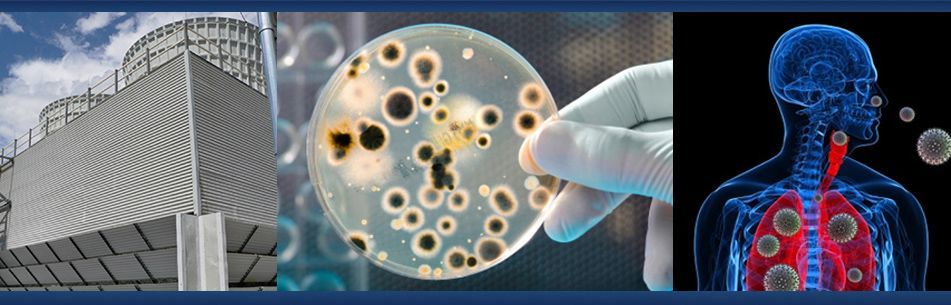

Welcome to our website
In Pursuite of Safety and Health!
Fast, reliable service
Whether you need help with sampling, regulations, compliance, and safety, advice on theoretical issues, or assistance with practical tasks, you can trust us to get the job done.
Discretion you can trust
Regardless of the subject matter, you can count on our full discretion: Your privacy is our highest priority. Contact us and see for yourself.
Expert consulting
With more 40 year of experience our highly qualified team is happy to assist you with any needs you may have, in both the private and commercial industry.
Our services
We guarantee fast and discrete handling of all your business tasks. Our team of highly qualified employees is available day and night – because your satisfaction is our highest priority.